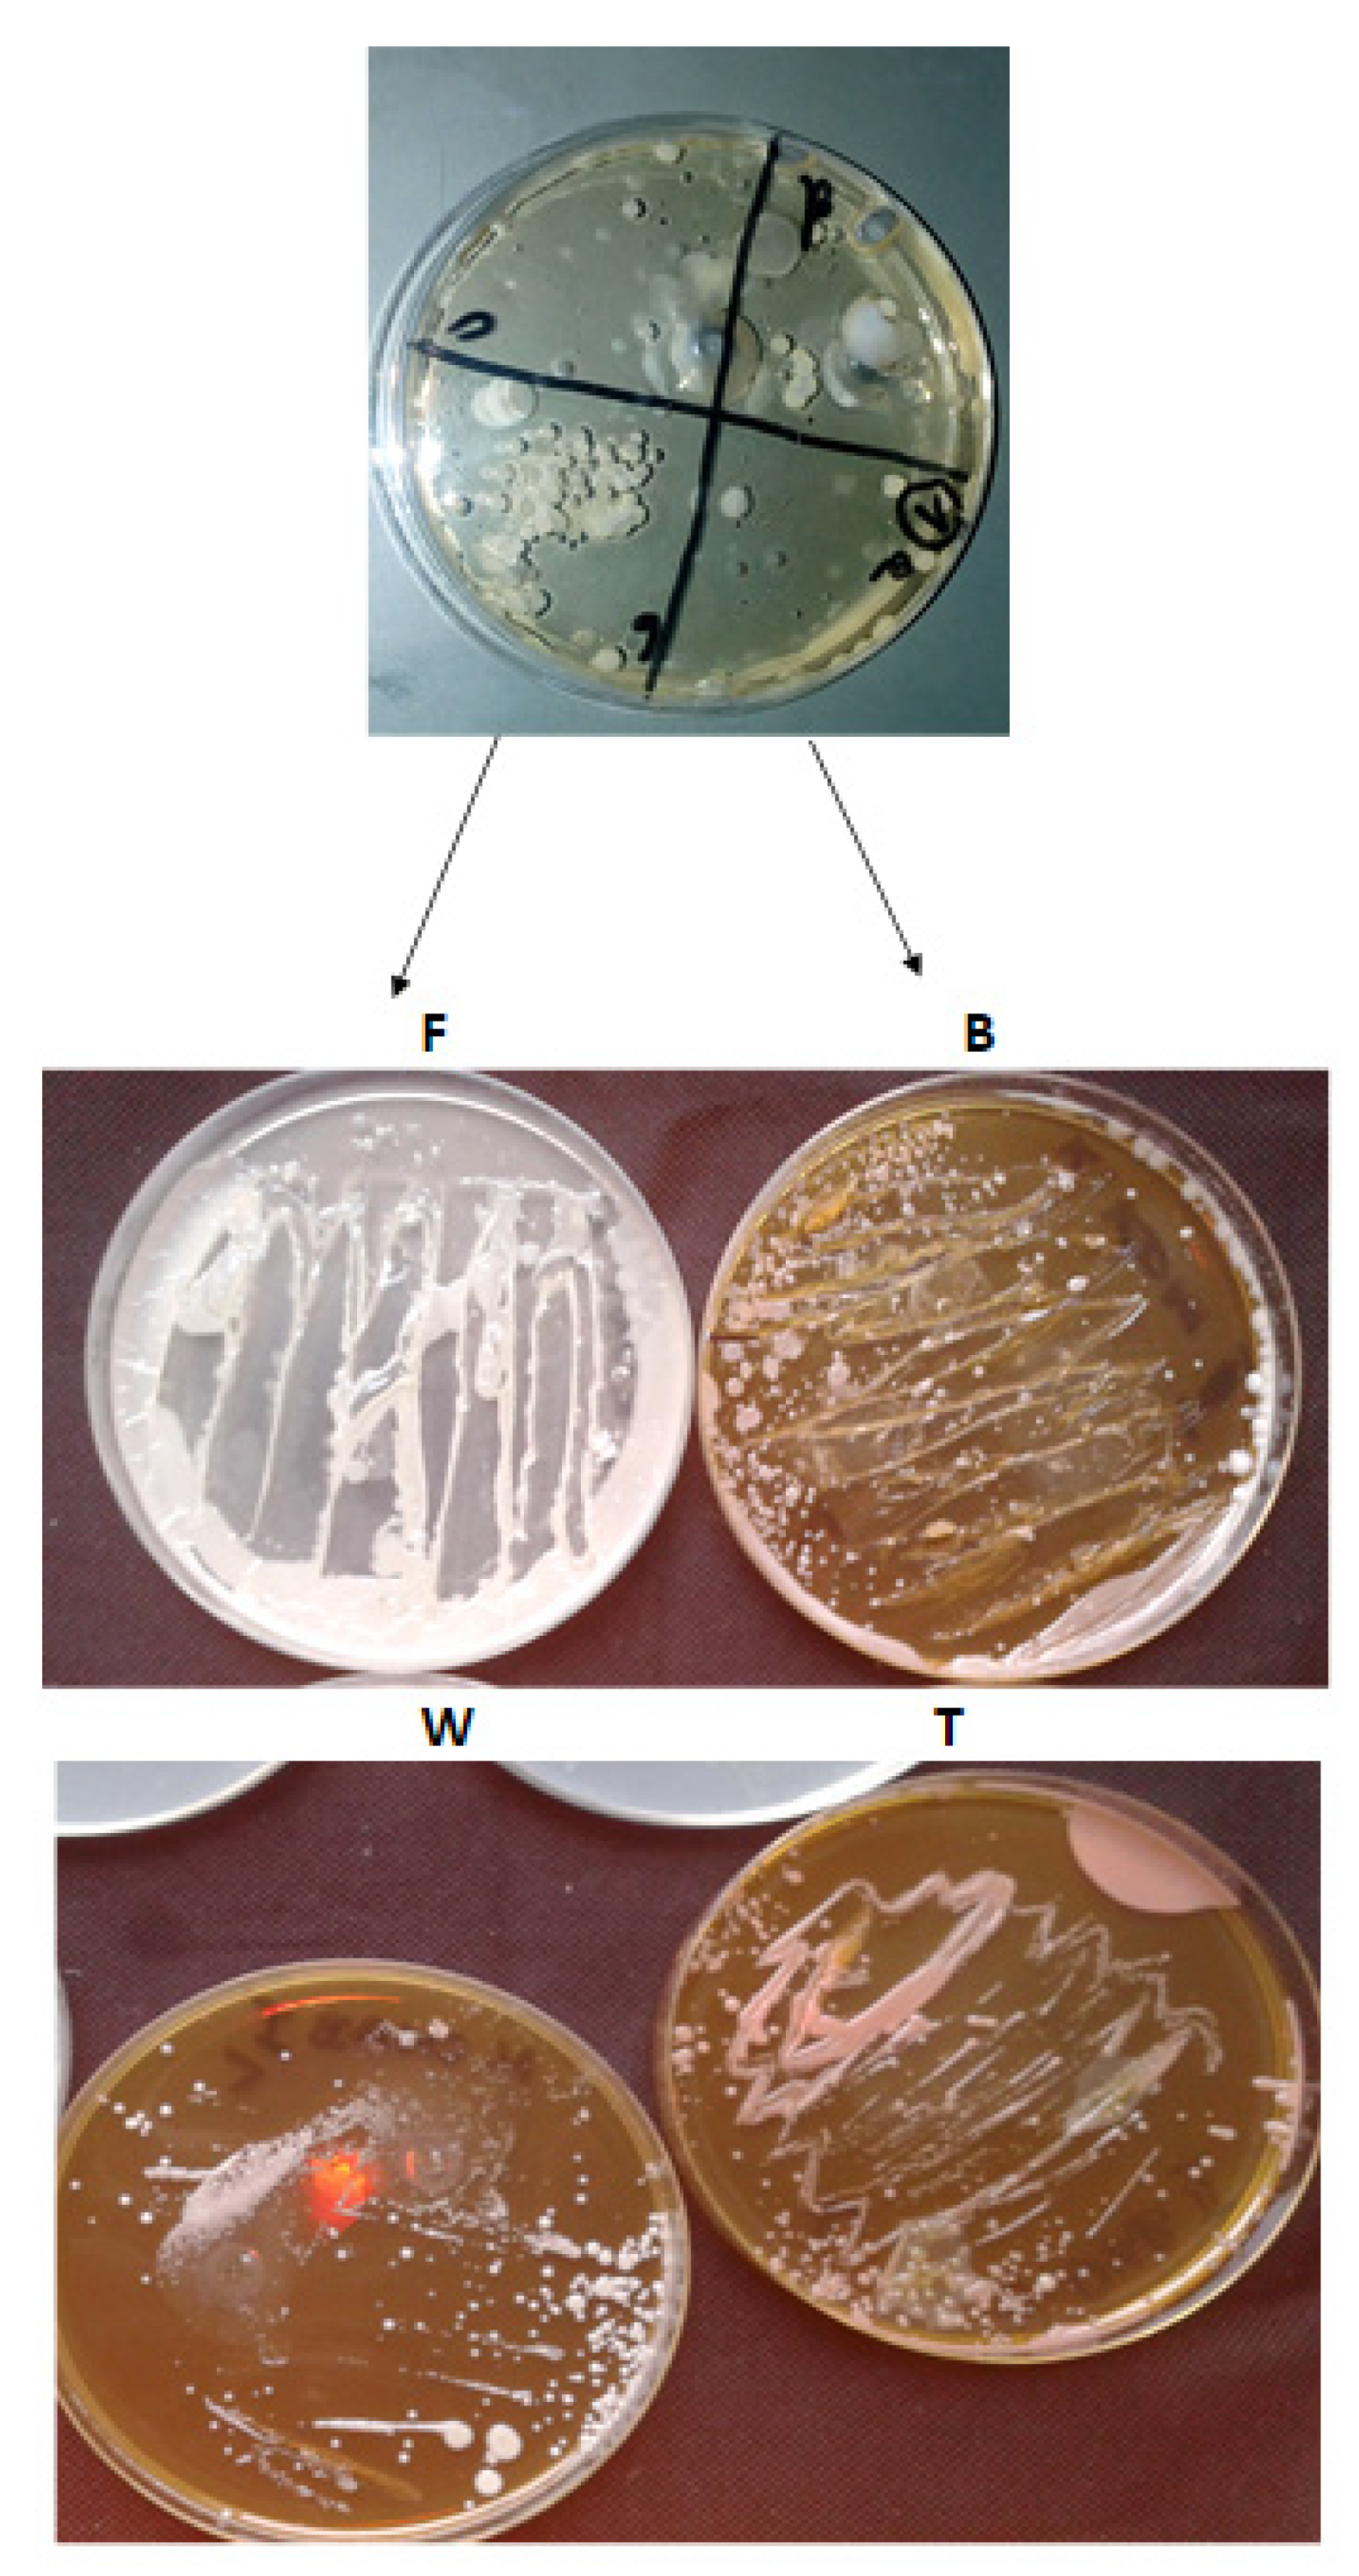
Materials 14 01372 g001

Impact of the Diet on the Formation of Oxidative Stress and Inflammation Induced by Bacterial Biofilm in the Oral Cavity
Abstract
1. Introduction
1.1. The Physiological Flora of the Oral Cavity
1.2. The Role of Nutrients in the Colonization of Microorganisms
- 1
- to estimate the influence of food on causing inflammation of soft tissues in the oral cavity in the presence of residual biofilm
- 2
- to estimate the effect of food on the supra- and subgingival biofilm, is it the same or different?
- 3
- to analyze the types of food in terms of the possibility of slowing down the development of inflammations in the oral cavity or rejecting the above possibility
- 4
- to estimate which products in the diet cause the greatest oxidation stress in the oral cavity of mammals.
2. Materials and Methods
2.1. Microorganisms and Media
2.2. Methodological Description Related to the Four Types of Diet
- standard oral hygiene for you—do not change your hygiene habits
- eat meals consisting mainly of products from the recommended diet (diet type F, B, W, T), and at least finish each meal with a product from the recommended diet
- on the third day of the diet, meeting at the MSCKZiU dental office in Toruń
- completing the documentation
- collection of the bacterial inoculum with saliva on plates with an appropriate culture medium (noninvasive collection—without breaking the tissue continuity)—procedure A
- performing hygienic and periodontal measurements (indicators)—procedure B
- removal of tartar—procedure C
- continuation of the recommended diet for the next 3 days.
- after next following 3 days, another bacterial inoculum with saliva on plates with an appropriate culture medium and sequencing (noninvasive collection—without damaging the tissue continuity)—procedure D.
- Mainly targeted at protein products
- You can eat other foods as well, but end each meal with a sugar-free protein product such as kefir, yoghurt, cheese, etc.
- Mainly oriented towards vegetables
- other foods can also be eaten, but each meal should end with vegetables, such as radish, watercress, kale, broccoli, kohlrabi, etc.
- Mainly targeted at foods containing Omega-3 fatty acids
- you can also eat other foods, but each meal should be finished with food containing Omega-3 fats, e.g., fish, especially salmon, herring, mackerel, sardines, seafood, sushi, rapeseed oil, linseed, soybean oil, soy products, nuts, almonds, pumpkin seeds.
- description and symbol of containers:
- A.
- material collected supragingivally before the procedure
- B.
- material collected before the procedure from the gingival fissure
- C.
- material collected supragingivally 3 days after the procedure
- D.
- material collected 3 days after collected material (surgery) from the gingival fissure
- pan coding:
- 1st item—ordinal number of the subject from the collective research document
- 2 diet item F or B or W or T
- 3rd position:
- supragingival material before the procedure—A
- material taken from the fissure before the procedure—B
- 3 days after the procedure, supragingival material—C
- 3 days after the treatment, material taken from the fissure—D
2.3. Analysis of Bacterial Biofilms
2.4. Statistical Analysis
3. Results
3.1. Research Techniques—Dental Indicators
3.2. Analysis of Bacterial Biofilms in Search of Periopathogens of Bacterial Complexes
3.3. Oral Microbiota Collected from Volunteers
4. Discussion
Analysis of Dental Indices in a Group of 20 Volunteers in Terms of the Effect of Diet on Soft Tissues in the Oral Cavity
- 1
- The magenta index visually determines the presence of plaque deposits: soft, hard and plaque. After averaging the results in each of the studied subgroups, the results were in the range between 2–3, which indicated a sufficient level of hygiene in each of the studied groups.
- 2
- The Pl.I index indicates the thickness of the bacterial plaque. After averaging the results in each of the studied subgroups, the results ranged between 1 and 2, which indicated good hygiene in each of the studied groups.
- 3
- The OHI index determines the presence of soft and hard bacterial plaque (tartar). After averaging the results in each of the studied subgroups, the results ranged between 1 and 2, which indicated good hygiene in each of the studied groups.
- 4
- The API index determines the presence of bacterial plaque in the interdental spaces, in places that are not easy to clean and favor its retention. When the results were averaged in the subgroups with diet B, T, W, the results were in the range of 53.38–69.72%, which indicated average hygiene. In the subgroup with diet F, the mean result was 82.42%, which meant poor hygiene.
- 5
- PBI determines the bleeding of the gums, which is one of the symptoms of inflammation of soft tissues. After averaging the results, it turned out that with diet W was 0.09%, with diet B it was 4.6% and with diet T it was 5.05%, which indicated clinically healthy periodontitis. With the F diet, this figure was 21.3%, which indicated moderate gingivitis. There was a noticeable difference between the control subgroup with diet F and the subgroups with diets W, B, T.
- 6
- CPITN index determines the need for specialist periodontal treatment. It should be noted here that in the subgroups with diets B and T there were two people with a need for periodontal treatment, which may have affected the mean result, and in the subgroups with diets W and F, one person each.
5. Conclusions
- 1
- The research group, when averaging the results, was at a similar level in terms of oral hygiene.
- 2
- Differences appeared when determining the API index, where lower parameters were noticed only in the F diet: it can be assumed that the diet is not insignificant when it comes to the deposition of bacterial plaque in the interdental spaces.
- 3
- Diet influences the inflammation of soft tissues. The most favorable results were seen in people on the W diet, and vegetables are largely vitamins, some of them antioxidants. Similar results were seen in people with diets B and T. However, it should be noted that in the last two subgroups there were two people eligible for periodontal treatment. In the above subgroups, people with sufficient/good hygiene according to the parameters of the indicators had clinically healthy periodontium.
- 4
- The difference between people on a strictly defined diet and people on the F diet (with a defined PBI index) differed by two degrees in the scale of interpretation of results and the condition was defined as moderate for this subgroup.
- 5
- Research clearly suggests that the elimination of carbohydrate-based products from food is significant for soft tissues, even with bacterial plaque.
- 6
- The best results were obtained by patients with diet W, where the average result was less than 0.1%
Author Contributions
Funding
Institutional Review Board Statement
Informed Consent Statement
Data Availability Statement
Conflicts of Interest
Abbreviations
| A. actinomycetemcomitans | Aggregatibacter actinomycetemcomitans |
| P. gingivalis | Porphyromonas gingivalis |
| T. forsythia | Tannerella forsythia |
| T. denticola | Treponema denticola |
| F. nucleatum | Fusobacterium nucleatum |
| P. intermedia | Prevotella intermedia |
| L. salivarius | Ligilactobacillus salivarius |
| S. pyogenes | Streptococcus pyogenes |
| S. sanguinis | Streptococcus sanguinis |
| S. mutans | Streptococcus mutans |
| L. delbrueckii | Ligilactobacillus delbrueckii |
| E. corrodens | Eikenella corrodens |
| C. concisus | Campylobacter concisus |
| V. parvula | Veillonella parvula |
| A. odontolyticus | Actinomyces odontolyticus |
| P. micros | Peptostreptococcus micros |
| E. nodatum | Eubacterium nodatum |
| S. constellatus | Streptococcus constellatus |
References
- Gibbons, R. Role of Adhesion in Microbial Colonization of Host Tissues: A Contribution of Oral Microbiology. J. Dent. Res. 1996, 75, 866–870. [Google Scholar] [CrossRef] [PubMed]
- Fagarasan, S.; Honjo, T. Intestinal IgA synthesis: Regulation of front-line body defences. Nat. Rev. Immunol. 2003, 3, 63–72. [Google Scholar] [CrossRef] [PubMed]
- Ammons, M.C.; Copie, V. Mini-review: Lactoferrin: A bioinspired, anti-biofilm therapeutic. Biofouling 2013, 29, 443–455. [Google Scholar] [CrossRef] [PubMed]
- Jenssen, H.; Hancock, R.E. Antimicrobial properties of lactoferrin. Biochimie 2009, 91, 19–29. [Google Scholar] [CrossRef] [PubMed]
- Baker, H.M.; Baker, E.N. Lactoferrin and Iron: Structural and dynamic aspects of binding and release. BioMetals 2004, 17, 209–216. [Google Scholar] [CrossRef] [PubMed]
- Berlutti, F.; Pilloni, A.; Pietropaoli, M.; Polimeni, A.; Valenti, P. Lactoferrin and oral diseases: Current status and perspective in periodontitis. Ann. Stomatol. 2012, 2, 10–18. [Google Scholar]
- Guo, Y.; Nguyen, K.-A.; Potempa, J. Dichotomy of gingipains action as virulence factors: From cleaving substrates with the precision of a surgeon’s knife to a meat chopper-like brutal degradation of proteins. Periodontology 2010, 54, 15–44. [Google Scholar] [CrossRef] [PubMed]
- Allaker, R.P.; Stephen, A.S. Use of Probiotics and Oral Health. Curr. Oral Heal. Rep. 2017, 4, 309–318. [Google Scholar] [CrossRef]
- Chaves, B.; Brashears, M.; Nightingale, K. Applications and safety considerations of Lactobacillus salivarius as a probiotic in animal and human health. J. Appl. Microbiol. 2017, 123, 18–28. [Google Scholar] [CrossRef] [PubMed]
- Darveau, R.P.; Hajishengallis, G.; Curtis, M.A. Porphyromonas gingivalis as a potential community activist for disease. J. Dent. Res. 2012, 91, 816–820. [Google Scholar] [CrossRef] [PubMed]
- Marsh, P.D. Dental plaque: Biological significance of a biofilm and community life-style. J. Clin. Periodontol. 2005, 32, 7–15. [Google Scholar] [CrossRef]
- Bassler, B.L.; Losick, R. Bacterially Speaking. Cell 2006, 125, 237–246. [Google Scholar] [CrossRef]
- Jayaram, P.; Chatterjee, A.; Raghunathan, V. Probiotics in the treatment of periodontal disease: A systematic review. J. Indian Soc. Periodontol. 2016, 20, 488–495. [Google Scholar] [CrossRef]
- Grenier, D.; Roy, S.; Chandad, F.; Plamondon, P.; Yoshioka, M.; Nakayama, K.; Mayrand, D. Effect of Inactivation of the Arg- and/or Lys-Gingipain Gene on Selected Virulence and Physiological Properties of Porphyromonas gingivalis. Infect. Immun. 2003, 71, 4742–4748. [Google Scholar] [CrossRef] [PubMed]
- Jagiellonian Innovation Center. In Vitro Test Report: “Antibacterial Action of the Salistat Diet Supplement Containing Lactobacillus Salivarius SGL 03, Lactoferrin, GOS and Lemon and Rosemary Oils on Streptococcus Pyogenes, Streptococcus Sanguinis and Streptococcus Mutans”. 2017. Available online: https://en.uj.edu.pl/research/innovation (accessed on 26 September 2020).
- Slavkin, H.C. Biofilms, microbial ecology and antoni van leeuwenhoek. J. Am. Dent. Assoc. 1997, 128, 492–495. [Google Scholar] [CrossRef] [PubMed]
- Kadowaki, T.; Baba, A.; Abe, N.; Takii, R.; Hashimoto, M.; Tsukuba, T.; Okazaki, S.; Suda, Y.; Asao, T.; Yamamoto, K. Suppression of pathogenicity of Porphyromonas gingivalis by newly developed gingipain inhibitors. Mol. Pharmacol. 2004, 66, 1599–1606. [Google Scholar] [CrossRef] [PubMed]
- Food and Agriculture Organization; World Health Organization. Guidelines for the Evaluation of Probiotics in Food—Report of a Joint FAO/WHO Working Group on Drafting Guidelines for the Evaluation of Probiotics in Food; Food and Agriculture Organization: Rome, Italy; World Health Organization: Geneva, Switzerland, 2002. [Google Scholar]
- Yeo, S.; Lee, S.; Park, H.; Shin, H.; Holzapfel, W.; Huh, C.S. Development of putative probiotics as feed additives: Validation in a porcine-specific gastrointestinal tract model. Appl. Microbiol. Biotechnol. 2016, 100, 10043–10054. [Google Scholar] [CrossRef]
- Ishida, N.; Ishihara, Y.; Ishida, K.; Tada, H.; Funaki-Kato, Y.; Hagiwara, M.; Ferdous, T.; Abdullah, M.; Mitani, A.; Michikawa, M.; et al. Periodontitis induced by bacterial infection exacerbates features of Alzheimer’s disease in transgenic mice. NPJ Aging Mech. Dis. 2017, 6, 3–15. [Google Scholar] [CrossRef]
- Jimenez, M.; Giovannucci, E.; Kaye, E.K.; Joshipura, K.J.; Dietrich, T. Predicted vitamin D status and incidence of tooth loss and periodontitis. Public Heal. Nutr. 2013, 17, 844–852. [Google Scholar] [CrossRef]
- Katz, J.; Chegini, N.; Shiverick, K.; Lamont, R. Localization of P. gingivalis in Preterm Delivery Placenta. J. Dent. Res. 2009, 88, 575–578. [Google Scholar] [CrossRef]
- Colombo, A.V.; Silva, C.M.; Haffajee, A.; Colombo, A.P.V. Identification of oral bacteria as-sociated with crevicular epithelial cells from chronic periodontitis lesions. J. Med. Microbiol. 2006, 55, 609–615. [Google Scholar] [CrossRef] [PubMed]
- Haffajee, A.D.; Socransky, S.S.; Patel, M.R.; Song, X. Microbial complexes in suprag-ingival plaque. Oral Microbiol. Immunol. 2008, 23, 196–205. [Google Scholar] [CrossRef]
- Nędzi-Góra, M.; Kowalski, J.; Krajewski, J.; Górska, R. Microbiological analysis of deep periodontal pockets in people with chronic periodontitis by PCR. Stomatol. J. 2007, 11, 717–725. [Google Scholar]
- Smiley, C.J.; Tracy, S.L.; Abt, E.; Michalowicz, B.S.; John, M.T.; Gunsolley, J.C.; Cobb, C.M.; Rossmann, J.A.; Harrel, S.K.; Forrest, J.L.; et al. Evidence-based clinical practice guideline on the nonsurgical treatment of chronic periodontitis by means of scaling and root planing with or without adjuncts. J. Am. Dent. Assoc. 2015, 146, 525–535. [Google Scholar] [CrossRef] [PubMed]
- Paik, S.; Senty, L.; Das, S.; Noe, J.C.; Munro, C.L.; Kitten, T. Identification of Virulence Determinants for Endocarditis in Streptococcus sanguinis by Signature-Tagged Mutagenesis. Infect. Immun. 2005, 73, 6064–6074. [Google Scholar] [CrossRef] [PubMed]
- Kaye, E.K.; Valencia, A.; Baba, N.; Spiro, A.; Dietrich, T.; Garcia, R.I. Tooth loss and periodontal disease predict poor cognitive function in older men. J. Am. Geriatr. Soc. 2010, 58, 713–718. [Google Scholar] [CrossRef]
- Socransky, S.S.; Haffajee, A.D.; Cugini, M.A.; Smith, C.; Kent, R.L., Jr. Microbial complexes in sub-gingival plaque. J. Clin. Periodontol. 1998, 25, 134–144. [Google Scholar] [CrossRef]
- Socransky, S.S.; Haffajee, A.D. Periodontal microbial ecology. Periodontology 2005, 38, 135–187. [Google Scholar] [CrossRef]
- Servin, A.L. Antagonistic activities of lactobacilli and bifidobacteria against micro-bial pathogens. FEMS Microbiol. Rev. 2004, 28, 405–440. [Google Scholar] [CrossRef]
- Sela, M.N. Role of Treponema denticola in periodontal diseases. Crit. Rev. Oral Biol. Med. 2001, 12, 399–413. [Google Scholar] [CrossRef]
- Haffajee, A.D.; Teles, R.P.; Socransky, S.S. The effect of periodontal therapy on the composition of the subgingival microbiota. Periodontology 2000, 42, 219–258. [Google Scholar] [CrossRef]
- Cutler, C.W.; Kalmar, J.R.; Genco, C.A. Pathogenic strategies of the oral anaerobe Porhyromonas gingivalis. Trends Microbiol. 1995, 3, 45–51. [Google Scholar] [CrossRef]
- Neville, B.A.; O’Toole, P.W. Probiotic properties of Lactobacillus salivarius and closely related Lactobacillus species. Future Microbiol. 2010, 5, 759–774. [Google Scholar] [CrossRef]
- Pidutti, P.; Federici, F.; Brandi, J.; Manna, L.; Rizzi, E.; Marini, U.; Cecconi, D. Purification and characterization of ribosomal proteins L27 and L30 having antimicrobial activity produced by the Lactobacillus salivarius SGL 03. J. Appl. Microbiol. 2018, 124, 398–407. [Google Scholar] [CrossRef]
- Sbordone, L.; DiGenio, M.; Bortolaia, C. Bacterial virulence in the etiology of peri-odontal diseases. Minerva Stomatol. 2000, 49, 485–500. [Google Scholar]
- Shimauchi, H.; Mayanagi, G.; Nakaya, S.; Minamibuchi, M.; Ito, Y.; Yamaki, K.; Hirata, H. Improvement of periodontal condition by probiotics with Lactobacillus salivarius WB21: A randomized, double-blind, placebo-controlled study. J. Clin. Periodontol. 2008, 35, 897–905. [Google Scholar] [CrossRef]
- Banach, J.; Dembowska, E.; Górska, R.; Jańczuk, Z. Practical Clinical Periodontology; Kwintesencja: Warsaw, Poland, 2004; ISBN 83-85700-42-0. [Google Scholar]
- Jańczuk, Z. Manual for Dental Assistants and Hygienists; PZWL: Warsaw, Poland, 2011; ISBN 978-83-200-4371-6. [Google Scholar]
- Mielczarek, A.; Kowalik, R.; Najman, M. Manual for Dental Assistants and Hygienists; PZWL: Warsaw, Poland, 2018; ISBN 978-83-200-5388-3. [Google Scholar]
- Kucia, M.; Wietrak, E.; Szymczak, M.; Kowalczyk, P. Effect of LigiLactobacillus salivarius and Other Natural Components against Anaerobic Periodontal Bacteria. Molecules 2020, 25, 4519. [Google Scholar] [CrossRef] [PubMed]
- Sanger, F.; Nicklen, S.; Coulson, A.R. DNA sequencing with chain-terminating inhibitors. Proc. Natl. Acad. Sci. USA 1977, 74, 5463–5467. [Google Scholar] [CrossRef]
- Persson, G.R.; Persson, R.E. Cardiovascular disease and periodontitis: An update on the associations and risk. J. Clin. Periodontol. 2008, 35 (Suppl. 8), 362–379. [Google Scholar] [CrossRef] [PubMed]
- Mayanagi, G.; Kimura, M.; Nakaya, S.; Hirata, H.; Sakamoto, M.; Benno, Y.; Shimauchi, H. Probiotic effects of orally administered Lactobacillus salivarius WB21-containing tablets on periodontopathic bacteria: A double-blinded, placebo-controlled, randomized clinical trial. J. Clin. periodontol. 2009, 36, 506–513. [Google Scholar] [CrossRef] [PubMed]
- Collins, M.D.; Wallbanks, S.; Lane, D.J.; Shah, J.; Nietupski, R.; Smida, J.; Dorsch, M.; Stackebrandt, E. Phylogenetic analysis of the genus Listeria based on reverse transcriptase sequencing of 16S rRNA. Int. J. Syst. Bacteriol. 1991, 41, 240–246. [Google Scholar] [CrossRef] [PubMed]
- Fiorillo, L.; Cervino, G.; Laino, L.; D’Amico, C.; Mauceri, R.; Tozum, T.F.; Gaeta, M.; Cicciù, M. Porphyromonas gingivalis, periodontal and systemic implications: A systematic review. Dent. J. 2019, 7, 114. [Google Scholar] [CrossRef] [PubMed]
- Luca, C.; Laino, L.F.; Herford, A.S.; Lauritano, F.; Giudice, G.L.; Famà, F.; Santoro, R.; Troiano, G.; Iannello, G.; Cicciù, M. Oral health impact profile in celiac patients: Analysis of recent findings in a literature review. Gastroenterol. Res. Pract. 2018, 2018, 7848735. [Google Scholar] [CrossRef]

| Test/Name | What Checks | Examines/Evaluates | Formula—Calculations | Interpretation of the Results |
|---|---|---|---|---|
| Magenta | stains the bacterial plaque | Entire dentition or 6 teeth (shortened)—one from each group of opposing teeth (16, 14, 11, 36, 34, 31) Incisors, premolars and molars on the outside and inside | F = magenta index X = sum of the buccal values Y = sum of values on the inside n = number of teeth tested F = x + y n | 0–2 = good 2–3 = satisfactory 4–6 = bad 0—no sediment 1—the deposit covers the tooth up to 1/3 2—the tooth deposit covers the tooth from 1/3 to 2/3 3—the deposit covers the tooth above 2/3 |
| OHI (Oral Hygiene Index) | Discoloration of dental plaque | 16_______11 I_______26 46_______I3 1_______36 upper molars, cheek surfaces lower molars lingual surfaces incisors labial surfaces | OHI = sum of DI and CI values all the examined teeth DI and CI are calculated separately, the 12 results are summed and divided by the 6 teeth Raid/Sediment DI Stone of CI | 0–1 = very good hygiene 1–2 = good 2–3 = sufficient over 3—insufficient 0—no tile/stone 1—soft bloom or limescale up to 1/3 2 —soft sediment or limescale up to 2/3 3—soft sediment or scale above 2/3 |
| Pl.I (Plaque Index) | Gingival index of the thickness of the plaque | 16___12 I____24_ 44 I___32____36 Four tooth surfaces are examined: inner, outer, distal and mesial | The values of all tooth surfaces are summed up and divided into 4 and further divided into 6 tested teeth Pl.I = sum of area values: 4 Number of tested teeth | 0 = healthy, pale pink gums 1 = mild inflammation 2 = moderate inflammation, red gingival margin, pressure bleeding 3 = severe inflammation, red, bleeding gums 0—no tile 1—a thin layer of the plate 2—plaque on observed gingival margin or on the tooth surface and in the fissure 3—abundant accumulation of concrements on the gingival margin and tooth |
| API (Aproximal Plaque Index) | Examination of the presence of plaque in the interdental spaces (can be dyed) | Interdental spaces in quadrants 1 and 3 from the inside, and in quadrants 2 and 4 from the outside | API = sum of spaces with plate x100 sum of the studied spaces | 70–100% = bad 69–40% = average 39–25% = fairly good, within 25% optimal +/− |
| PBI (SBI) (Papilla Bleding Index) | Gingival—bleeding gums | Interdental spaces in quadrants 1 and 3 from the outside, and in quadrants 2 and 4 from the inside | PBI = sum of bleeding spaces x100 sum of the studied spaces | 50–100%= severe and unlimited gingivitis 20–50%= moderate gingivitis 10–20% = mild/condition requiring improvement of oral hygiene Less than 10% = periodontitis clinically healthy +/− |
| PSI (Parodontaler Screening Index) CPITN (Community Periodontal Index of Treatment Needs) | Indicator of periodontal treatment needs | 6 measuring points on each tooth in sextants page. outer proximal, middle, distal page. inner closer, middle, distal Children and adolescents—central incisors and first molars WHO probe | Only the lowest measuring point is recorded ‘measuring 4 in the sextant advances to the next sextant | 0 = no further therapy needed 2 = professional removal of subgingival concrements, correction of fillings and prosthetic works 3 and 4 = in any sextant, it is necessary to use periodontal treatment methods after initial therapy +/− 1 = black section of WHO probe fully visible + bleeding,—plaque 2 = black section of WHO probe fully visible + bleeding, + deposits 3 = black section of WHO probe partially visible +/− bleeding, +/– deposits 4 = black section of WHO probe not visible +/– bleeding, +/– deposits |
| No | Cod | Magenta Indicator | Indicator. Pl.I Inflammation | Indicator. OHI | Indicator. API | Indicator. PBI | Indicator. PSI/CPITN | Diet | Container. A | Container. B | Container. C | Container. D |
|---|---|---|---|---|---|---|---|---|---|---|---|---|
| 1 | 01.B.(A,B,C,D) | 2.2 (good) | 1.75 mild | 1.1 good | 60% average | 15% mild, needs improvement | 0 (does not require but perio.) | B | 5.09.2020 | 5.09.2020 | 8.09.2020 | 8.09.2020 |
| 2 | 02.B.(A,B,C,D) | 3 sufficient | 1.2 mild | 2 sufficient | 84% bad | 0% healthy periodontium | 0 (does not require but perio.) | B | 7.09.2020 | 7.09.2020 | 10.09.2020 | 10.09.2020 |
| 3 | 03.F.(A,B,C,D) | 2 good | 1.25 mild | 1.75 good | 91.6% bad | 66.6% severe gingivitis | 3 the patient is eligible for periodontal treatment | F | 7.09.2020 | 7.09.2020 | 10.09.2020 | 10.09.2020 |
| 4 | 04.W.(A,B,C,D) | 3.3 sufficient | 2.66 moderate | 3.25 insufficient | 100% bad | 0% healthy periodontium | 0 (does not require but perio.) | W | 8.09.2020 | 8.09.2020 | 11.09.2020 | 11.09.2020 |
| 5 | 05.F.(A,B,C,D) | 2.5 sufficient | 1.69 mild | 3.66 insufficient | 94% bad | 23.53% moderate gingivitis | 0 (does not require but perio.) | F | 8.09.2020 | 8.09.2020 | 11.09.2020 | 11.09.2020 |
| 6 | 06.T.(A,B,C,D) | 2.83 sufficient | 1.5 mild | 1 good | 57.14% average | 10.71 condition requiring improvement of hygiene | 0 (does not require but perio.) | T | 9.09.2020 | 9.09.2020 | 12.09.2020 | 12.09.2020 |
| 7 | 07.T.(A,B,C,D) | 1.83 good | 0.63 healthy gums | 0.5 very good | 18.18% improvement of hygiene | 0% periodontium wedge. healthy | 0 (does not require but perio.) | T | 9.09.2020 | 9.09.2020 | 12.09.2020 | 12.09.2020 |
| 8 | 08.B.(A,B,C,D) | 1.5 good | 1.79 mild | 0.9 good | 83.33% bad | 0% periodontium wedge. healthy | 3 the patient is eligible for periodontal treatment | B | 10.09.2020 | 10.09.2020 | 14.09.2020 | 14.09.2020 |
| 9 | 09.B.(A,B,C,D) | 2 good | 1.33 mild | 1.83 good | 28% good | 8% moderate gingivitis | 0 (does not require but perio.) | B | 10.09.2020 | 10.09.2020 | 14.09.2020 | 14.09.2020 |
| 10 | 10.B.(A,B,C,D) | 2.6 sufficient | 1.55 good | 1.25 good | 59.09% average | 0% periodontium wedge. healthy | 3 the patient is eligible for periodontal treatment | B | 12.09.2020 | 12.09.2020 | 15.09.2020 | 15.09.2020 |
| 11 | 11.T.(A,B,C,D) | 1.67 good | 1.17 mild | 1.08 good | 35.71% good | 10.71% condition requiring improvement of hygiene | 4 the patient is needs for periodontal treatment | T | 12.09.2020 | 12.09.2020 | 15.09.2020 | 15.09.2020 |
| 12 | 12.T.(A,B,C,D) | 3.83 bad | 2.08 moderate | 1.67 good | 90.48% bad | 0% periodontium wedge. healthy | 3 the patient is eligible for periodontal treatment | T | 14.09.2020 | 14.09.2020 | 17.09.2020 | 17.09.2020 |
| 13 | 13.T.(A,B,C,D) | 2.5 sufficient | 1.83 mild | 1.08 good | 65.38% average | 3.85 % clinically healthy | 1 (does not require but perio.) | T | 15.09.2020 | 15.09.2020 | 18.09.2020 | 18.09.2020 |
| 14 | 14.W.(A,B,C,D) | 3.5 sufficient | 1.83 mild | 1.25 good | 52% average | 0% periodontium wedge. healthy | 3 the patient is eligible for periodontal treatment | W | 15.09.2020 | 15.09.2020 | 18.09.2020 | 18.09.2020 |
| 15 | 15.F.(A,B,C,D) | 4 bad | 2.38 moderate | 1.25 good | 84.21% bad | 5.26% clinically healthy | 2 (does not require but perio.) | F | 16.09.2020 | 16.09.2020 | 19.09.2020 | 19.09.2020 |
| 16 | 16.W.(A,B,C,D) | 3 sufficient | 2 moderate | 1.58 good | 89.29% bad | 0% periodontium wedge. healthy | 2 (does not require but perio.) | W | 16.09.2020 | 16.09.2020 | 19.09.2020 | 19.09.2020 |
| 17 | 17.W.(A,B,C,D) | 2.17 sufficient | 1.46 mild | 1 very good | 16% optimal | 0% periodontium wedge. healthy | 1 (does not require but perio.) | W | 17.09.2020 | 17.09.2020 | 20.09.2020 | 20.09.2020 |
| 18 | 18.W.(A,B,C,D) | 2 good | 1.63 mild | 0.83 very good | 91.3% bad | 0.43% periodontium wedge. healthy | 2 (does not require but perio.) | W | 17.09.2020 | 17.09.2020 | 20.09.2020 | 20.09.2020 |
| 19 | 19.F.(A,B,C,D) | 2 good | 1.79 mild | 1.17 good | 90.47% bad | 0% periodontium wedge. healthy | 2 (does not require but perio.) | F | 18.09.2020 | 18.09.2020 | 21.09.2020 | 21.09.2020 |
| 20 | 20.F.(A,B,C,D) | 3.5 sufficient | 2.13 mild | 2 good/sufficient | 51.85% average | 11,11 in need of improved hygiene | 2 (does not require but perio.) | F | 19.09.2020 | 19.09.2020 | 22.09.2020 | 22.09.2020 |
| lp | Type | lp | Type | lp | Type | lp | Type |
|---|---|---|---|---|---|---|---|
| 1a | Propionibacterium acnes | 1b | Arachnia propionica (Actinomyces propionicus) | 1c | Bifidobacterium dentium | 1d | Eubakterium timidum |
| 2a | Streptococcus constellatus | 2b | Streptococcus oralis | 2c | Streptococcus mitis | 2d | Prevotella nigrescens |
| 3a | Streptococcus pygenes | 3b | Streptococcus mutans | 3c | Streptococcus sanguinis | 3d | Streptococcus gordonii |
| 4a | Capnocytophaga ochracea | 4b | Capnocytophaga sputigena | 4c | Capylobacter concisus | 4d | Capnocytophaga ochracea |
| 5a | Rothia dentocariosa | 5a | Rothia dentocariosa | 5c | Trichomonas tenax | 5d | Treponema denticola |
| 6a | Lactobacillus acidophilus | 6b | Lactobacillus buchneri | 6c | Bifidobacterium dentium | 6d | Bifidobacterium dentium |
| 7a | Lactobacillus casei | 7b | Lactobacillus plantarum | 7c | Lactobacillus fermentum | 7d | Lactobacillus salivarius |
| 8a | Streptococcus sanguinis | 8b | Peptostreptococcus micros | 8c | Peptostreptococcus micros | 8d | Streptococcus gordoni |
| 9a | E. coli R2 | 9b | Lactobacillus buchneri | 9c | Bifidobacterium dentium | 9d | Lactobacillus casei |
| 10a | E. coli R4 | 10b | E.coli R4 | 10c | Lactobacillus casei | 10d | Lactobacillus plantarum |
| 11a | E. coli R3 | 11b | Propionibacterium acnes | 11c | Propionibacterium acnes | 11d | Desulfococcus oleovorans Hxd3 |
| 12a | Tanarella forsythia | 12b | Tanarella forsythia | 12c | Tanarella forsythia | 12d | Tanarella forsythia |
| 13a | Escherichia. coli R2 | 13b | Escherichia. coli R2 | 13c | Escherichia. coli R2 | 13d | Eubacterium nodatum |
| 14a | Pyrococcus sp. OT3 | 14b | Pyrococcus sp. OT3 | 14c | Pyrococcus sp. OT3 | 14d | Pyrococcus sp. OT3 |
| 15a | Porhyromonas gingivalis | 15b | Actinomyces odontolyticus | 15c | Peptostreptococcus micros | 15d | Peptostreptococcus micros |
| 16a | Thermospiro melanesiensis BI429 | 16b | Thermanaerovibrio acidaminovorans DSM 6589 | 16c | Treponema denticola | 16d | Treponema denticola |
| 17a | E. coli R3 | 17b | Lactobacillus buchneri | 17c | Bifidobacterium dentium | 17d | Desulfonatronospira thiodismutans Aso3-1 |
| 18a | Fusobacterium nucleatum | 18b | Fusobacterium nucleatum | 18c | Fusobacterium polymorphum | 18d | Fusobacterium polymorphum |
| 19a | Actinomyces odontolyticus | 19b | Actinomycesmeyeri | 19c | Escherichia. coli R2 | 19d | Eubacterium nodarum |
| 20a | Escherichia. coli R3 | 20b | Lactobacillus delbrueckii | 20c | Bifidobacterium dentium | 20d | Arachnia propionica |
| No of Patients/Type of Diet in Indicator | 1B | 2B | 3B | 4B | 5B | 6T | 7T | 8T | 9T | 10T | 11W | 12W | 13W | 14W | 15W | 16F | 17F | 18F | 19F | 20F |
|---|---|---|---|---|---|---|---|---|---|---|---|---|---|---|---|---|---|---|---|---|
| Indicator API | * | * | * | * | * | * | * | * | * | * | * | * | *** | *** | *** | ** | *** | |||
| Indicator PBI | ** | * | * | * | * | * | * | * | * | * | * | * | ** | ** | ** | ** |
Publisher’s Note: MDPI stays neutral with regard to jurisdictional claims in published maps and institutional affiliations. |
© 2021 by the authors. Licensee MDPI, Basel, Switzerland. This article is an open access article distributed under the terms and conditions of the Creative Commons Attribution (CC BY) license (http://creativecommons.org/licenses/by/4.0/).
Share and Cite
Rowińska, I.; Szyperska-Ślaska, A.; Zariczny, P.; Pasławski, R.; Kramkowski, K.; Kowalczyk, P. Impact of the Diet on the Formation of Oxidative Stress and Inflammation Induced by Bacterial Biofilm in the Oral Cavity. Materials 2021, 14, 1372. https://doi.org/10.3390/ma14061372
Rowińska I, Szyperska-Ślaska A, Zariczny P, Pasławski R, Kramkowski K, Kowalczyk P. Impact of the Diet on the Formation of Oxidative Stress and Inflammation Induced by Bacterial Biofilm in the Oral Cavity. Materials. 2021; 14(6):1372. https://doi.org/10.3390/ma14061372
Chicago/Turabian StyleRowińska, Ilona, Adrianna Szyperska-Ślaska, Piotr Zariczny, Robert Pasławski, Karol Kramkowski, and Paweł Kowalczyk. 2021. "Impact of the Diet on the Formation of Oxidative Stress and Inflammation Induced by Bacterial Biofilm in the Oral Cavity" Materials 14, no. 6: 1372. https://doi.org/10.3390/ma14061372
APA StyleRowińska, I., Szyperska-Ślaska, A., Zariczny, P., Pasławski, R., Kramkowski, K., & Kowalczyk, P. (2021). Impact of the Diet on the Formation of Oxidative Stress and Inflammation Induced by Bacterial Biofilm in the Oral Cavity. Materials, 14(6), 1372. https://doi.org/10.3390/ma14061372

